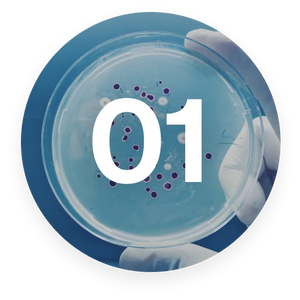

Featured on
Meet Dr. Gina Sam MD, New York City’s Most Prominent Liver and Metabolic Health Expert
Fatigue, stubborn belly fat, and body toxicity have become alarmingly common in my patients, often with no effective solutions in sight. Akka is a breakthrough for these challenges, targeting liver health with natural, science-backed ingredients.
Akka supports detoxification, reduces fat accumulation, and helps the liver regain its full metabolic potential. I am proud to endorse Akka as an effective, science-driven formula that provides my patients with real, lasting improvements in their energy levels, metabolism, and overall vitality. It’s helping them lead healthier, more vibrant lives.
Dr. Gina Sam M.D
Top Gastroenterologist 2024
Dr. Gina Sam is a renowned New York City gastroenterologist and former director of the Mount Sinai Gastrointestinal Motility Center.
Over her 20-year career, Dr. Sam has specialized in treating liver and metabolic disorders, founding the Institute of Gastrointestinal Motility Disorders and Integrative Health in New York City. Her groundbreaking work has positioned her at the forefront of understanding the root causes of fatigue, stubborn belly fat, body toxicity, and other metabolic dysfunctions. Dr. Sam’s expertise and patient-focused care have helped countless individuals regain control of their health and feel their best.
The Liver Is Responsible for 500 Critical Functions in the Body
A healthy liver can easily metabolize fats and toxins, burning calories efficiently, and giving you clean energy all day long.A weakened liver causes toxic accumulation and damage to nearly every cell, organ, and tissue inside your body. Including:
- Unexplained weight gain
- Brain fog and memory loss
- Accumulation of blood sugar and cholesterol
- Headaches from accumulating toxins in the blood
- Fatigue and daytime tiredness
- Loss of taste or smell
- Ringing in the ears
- Dark circles under the eyes
- Itchy skin and hands
- Stubborn, hard-to-lose belly fat
How Liver Works
"I was struggling with chronic fatigue and auto-immune problems. I was constantly breaking out in rashes and itching all over my body. Akka gave me a 'clean body' feeling in just a few weeks andI couldn't be happier. Amazing focus and concentration. I feel 20 years younger."
Michael G. ⭐⭐⭐⭐⭐
Why Researchers Are Calling Akkermansia The World's First Next-Generation Superbiotic…
Akkermansia is a groundbreaking probiotic that supports your liver, boosts your metabolism, and helps you feel your absolute best.
It’s a naturally occurring part of most people’s gut flora, but due to environmental toxins, poor lifestyle habits, antibiotic use, and almost everything peddled by big pharma, it's critically low in many people.
Studies show people with low levels of Akkermansia often struggle with issues like stubborn belly fat, fatigue, and even liver degeneration.
Here’s why it’s so powerful: Akkermansia strengthens your gut lining, preventing toxins from leaking into your bloodstream. This means better energy, less brain fog, improved digestion, and relief from skin irritations and bad breath. It also naturally produces GLP-1, a hormone that boosts metabolism, reduces cravings, and promotes fat loss—even on a high-fat diet!
Akkermansia Studies: A Revolution in Liver and Metabolic Health
Research into Akkermansia has uncovered groundbreaking health benefits, linking this superbiotic to improved liver function, metabolic health, and reduced disease risks.
One study revealed that individuals with diabetes had significantly lower levels of Akkermansia in their gut, a finding also associated with obesity. Further research found that obese mammals had 3,300 times less Akkermansia compared to their lean counterparts, underscoring its role in weight regulation.
A Duke School of Medicine study linked low Akkermansia levels to cardiovascular disease, showing its impact on heart health.
Here’s why it’s so powerful: Akkermansia strengthens your gut lining, preventing toxins from leaking into your bloodstream. This means better energy, less brain fog, improved digestion, and relief from skin irritations and bad breath. It also naturally produces GLP-1, a hormone that boosts metabolism, reduces cravings, and promotes fat loss—even on a high-fat diet!
Akka has helped thousands of people with liver issues to successfully lose weight and improve their daily life.
Why Akkermansia Makes Other Probiotics Obsolete
Why Akkermansia Makes
Other Probiotics Obsolete
Akkermansia secretes GLP-1, which boosts metabolism and reduces weight even when the animals are fed a high-fat diet!
GLP-1 massively reduces cravings that lead to weight loss.
That's why Akkermansia is genuinely nature's Ozempic - but without the nasty side effects.
How "Preserve Pasteurized" Akkermansia
Is The Only Choice For Liver Rejuvenation Without Side Effects
Is The Only Choice For Liver Rejuvenation Without Side Effects
At least a dozen studies have proven that the pasteurized version is far superior in terms of health benefits.
A 2020 study first discovered this ”We discovered that pasteurization of Akkermansia enhanced its capacity to reduce fat mass development, insulin resistance, and cholesterol.”
Another study confirmed this finding “We show that pasteurized Akermansia exerts positive effects on different metabolic parameters such as body weight, fat mass, insulin, glycemia and glucose tolerance.”
Yet another study published in 2021 concluded, “Notably pasteurized Akkermansia had been more effective. Treatment with the pasteurized form more effectively upregulated tight junction [reducing leaky gut] and regulated immune response-related genes. All of these effects were dominantly observed in the pasteurized form."
Our unique Preserve Pasteurized Akkermansia is more bio-absorbable and in a hibernating state, like gut-healing, liver-repairing soldiers suspended in time, just waiting for their chance to spring into action. We believePreserve Pasteurized Akkermansia is far superior in almost every category for weight loss, cardiovascular protection, cholesterol elimination, and liver regeneration and detoxification.
Akka Benefits
Akka focuses on liver regeneration and detoxification, unclogging bile ducts, healing and clearing out old scar tissue, and eliminating excess fat from the liver.
Increase energy and metabolism, relieving symptoms of lethargy, fatigue, and brain fog
Reduce bloating, indigestion, and inability to lose weight
Regulate mood and immunity, improving overall well-being and vitality
Akka's Clinically
Researched Ingredients
What makes Akka differentthan other probiotic products
We are witnessing an unprecedented epidemic of people turning to GLP-1 meds.
Ozempic is a synthetic drug designed to mimic GLP-1, a hormone that helps regulate blood sugar and reduce appetite. And yes, it can work temporarily for weight loss.
But here’s the problem: Ozempic forces your body into an artificial hormonal state, often leading to side effects like nausea, vomiting, fatigue, and muscle weakness.
Even more concerning, Ozempic only treats the symptoms—it doesn’t address the root cause of weight gain: an overburdened liver and an unhealthy gut.
A toxic liver struggles to metabolize fat, detoxify the body, and regulate hormones like GLP-1 naturally. When your liver isn’t functioning properly, no amount of external GLP-1 stimulation can truly fix the problem.
And let’s not forget the long-term risks. Many Ozempic users report severe dependency and rebound weight gain when they stop taking the drug.
Now imagine achieving those same metabolism-boosting, fat-burning benefits naturally—without the side effects. That’s where Akka comes in.
|   |
|
Others |
|---|---|---|
| Digestion | ||
| Microbiome | ||
| Liver | ||
| Blood Sugar | ||
| Immunity | ||
| Antioxidant |
Akka helps your liver produce GLP-1 on its own, and boosts your body’s natural ability to do this for good. It supports your liver’s natural ability to burn fat, regulate cravings, and boost energy—all while promoting long-term health.
Customer Reviews
FAQs
Are there any side effects? Is it safe to take it long term?
Are there any side effects? Is it safe to take it long term?
Akka superbiotic, with our Preserve Pasteurized preparation, has had zero reported side effects, and is one of the most powerful health-boosting formulations to exist in the last 20 years.
In fact, the only side effects related to Akkermansia are associated with the live version, which is what motivated us to develop our Preserve Pasteurized preparation.
The best part is, studies show this version to be far more effective for boosting the metabolism, burning fat and reducing fatigue.
In addition, Akka is considered a master superbiotic because it feeds the other beneficial probiotic strains already in your gut.
That means not only are you populating your microbiome with Akkermansia, you’re also increasing other health-promoting strains across the board.
This is important because many scientific studies have established a link between microbiome diversity and health.
In fact, low microbiome diversity, meaning not enough beneficial strains in the gut, has been linked in studies to many things like allergies, low sex drive, eczema, arthritis, cancer, chronic fatigue, autism, depression, enlarged prostate, anxiety, sleep disorder, HIV susceptibility, auto-immune problems like Crohn's and colitis, arterial plaque, hypertension, and gout.
And of course, while it would be a stretch to claim Akka will cure these problems, since there’s so many lifestyle factors involved, it will improve your microbiome dramatically and move things into a more healthy direction, and keep improving your health long-term.
How much weight can I lose with Akka Superbiotics?
How much weight can I lose with Akka Superbiotics?
Because the liver is the most critical organ in the body for eliminating fat and losing weight, Akka Superbiotics helps rejuvenate the liver, supercharging its ability to burn fat and detoxify your body.
Your weight loss with Akka is going to depend on many things, and here they are:
First… It's based on your starting point. If you’re significantly overweight, your bile ducts are clogged and your metabolism has been slowed, it might take a bit longer for your liver to rejuvenate, and burn all that fat.
Second… It's also based on your lifestyle factors. Here's what I mean. If you continue eating the 3 liver-toxic foods - sugar, alcohol, and trans fats, then you're going to have a tougher time because it's a bit like walking up a hill.
You'll get there but it's going to take Akka a little longer, and a bit more energy.
Once your liver reaches its full function, you'll know because it's likely you'll feel more energy, more clarity of mind, more focus, and renewed optimism for life.
The mental benefits are usually felt first, with the accelerated weight loss and fat burning ability kicking in about 2-4 weeks later.
What happens if I lose weight too quickly?
What happens if I lose weight too quickly?
Usually, it's bad to lose weight too quickly - but here’s how Akka Superbiotics changes that.
You see… Fat surrounds and protects organs from toxins. When the fat dissolves, the toxins are released into the bloodstream.
When your liver is damaged, clogged or unhealthy, it struggles to process all those released toxins.
However, because Akka helps give you a strong, rejuvenated and healthy liver, you'll have no problem handling the detoxification process that happens when you start burning stored body fat.
That said, most doctors recommend losing 2 pounds per week. If you find that you're losing weight faster than you want when taking Akka, simply taper the dose back to one capsule per day.
What else can harm the liver? I suspect I have liver problems because of my difficulty with weight loss, but I don't drink alcohol and I don’t consume a lot of sugar.
What else can harm the liver? I suspect I have liver problems because of my difficulty with weight loss, but I don't drink alcohol and I don’t consume a lot of sugar.
Remember, your liver is your body’s central filtration system for toxins. It’s also responsible for clearing cholesterol and removing fats from the bloodstream.
It has such an essential role in the body that a person would not even live for more than one day without a liver.
So there’s many other things that can cause problems with the liver, including drugs and medicines as well as environmental toxins, which would include exhaust from cars and airplanes, air pollution from factories and big cities.
Even if you avoid going outside or wear a mask, all kinds of pollution get into our water supply, which leeches into the skin while taking a shower.
Even if you have a whole-home water filter, you’re still getting pesticides, preservatives, and plastics from the food supply.
So, our liver has a critical job, and it’s no wonder why it’s overburdened in today’s society. Above and beyond that, the liver can be affected by viruses, mold, and bacteria, and can also be damaged by Big Pharma’s imperfect solutions to these outbreaks.
In fact, there has been a sharp increase in liver-related weight gain since 2020, and I think it’s not a coincidence, given the health epidemic that took place during that time period.
Lots of new research is coming out that shows just how fragile the liver really is and how important it is to take this important step on the road back to health and healing.
What makes Akka superior to probiotics?
What makes Akka superior to probiotics?
There’s three main points that make Akka superior to any probiotic out there.
Firstly, researchers consider Akkermansia to be a next-generation superbiotic—in that it actually feeds all of the beneficial probiotics already in your system and has provable benefits far beyond those of run-of-the-mill commercially available probiotics.
Above and beyond that, our proprietary Preserve Pasteurized technology makes our Akkermansia more bioavailable and usable by your body.
Remember, Preserve Pasteurized keeps the delicate Akkermansia in a peaceful state of hibernation, fully intact and ready for your body to be use.
This time-consuming process increases the bioavailability of the Akkermansia to ensure you get the full liver-regenerating, metabolism-boosting benefits.
Secondly, we have combined Akkermansia with several other liver-healing ingredients that have been shown in studies to be synergistic, further boosting the fat-burning, liver-rejuvenating properties.
And third, we use enteric coated capsules to protect and transport the ingredients through the stomach's harsh acidic environment, to deliver Akka straight to where it needs to be – the microbiome.
You won’t find a superior formulation in a supermarket, online, or anywhere else, guaranteed.